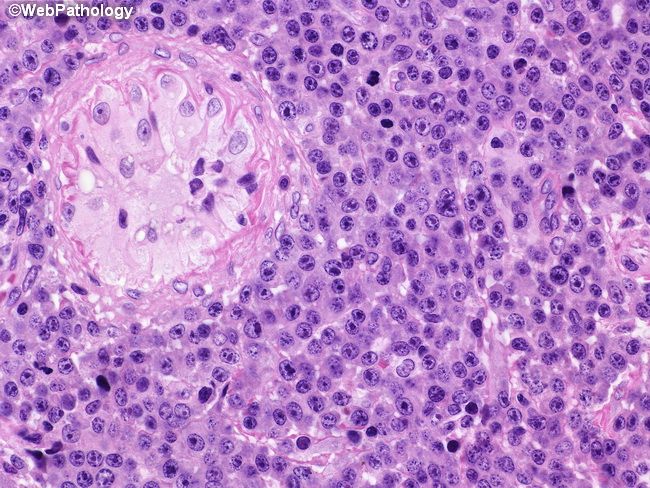
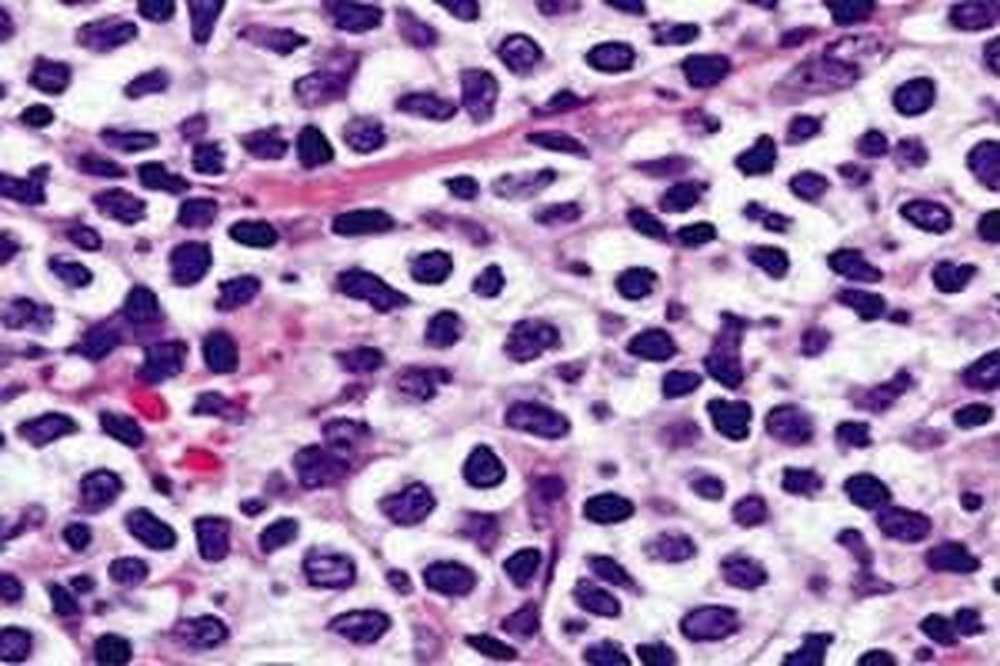
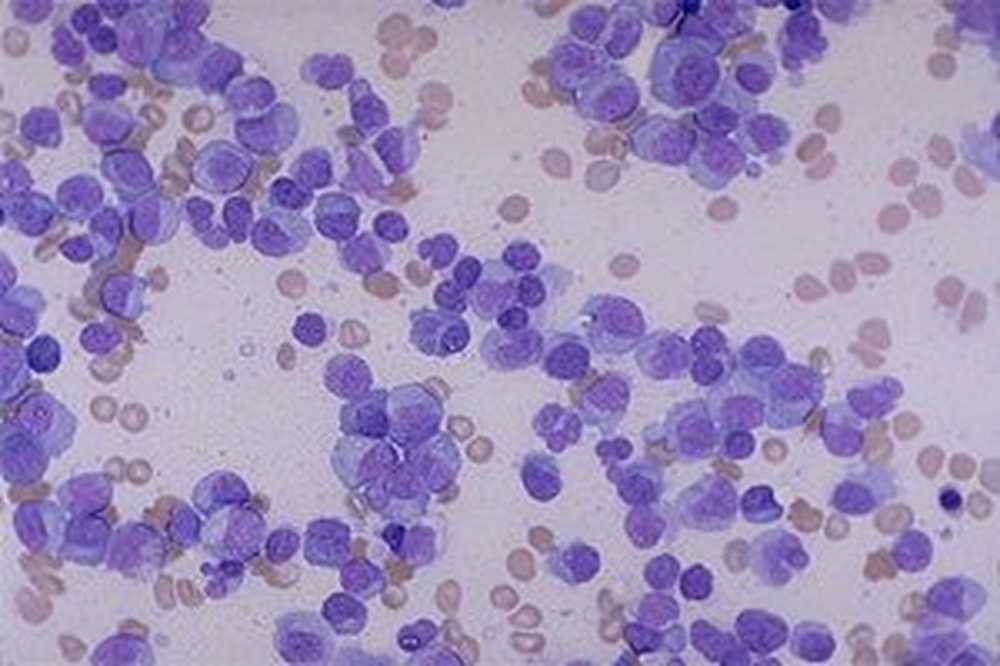

Плазмоцитома лечение
Русский язык 8 класс разумовская упражнение 44
Xfit нижний
Ктп математика 5 кл
Btl super inductive system
Массаж головы краснодар
Das wird es sein
Пересказ оливера твиста
С авито кошелька вернуть деньги на карту
Госуслуги получение электронных писем
Расписка или расписка в получении денег
Как стимулировать кишечник к опорожнению
Как записать площадь квадрата
Насос dp 40
Плазмоцитома лечение 118 фотографий